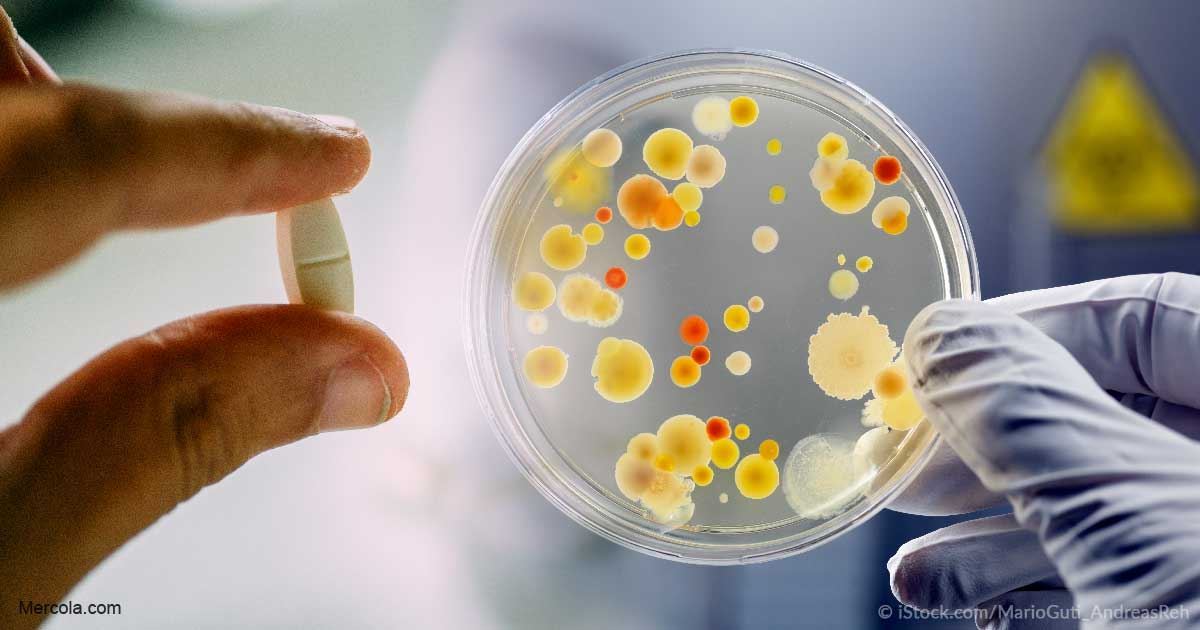

محققان استرالیا...بازگشت آنتیبیوتیک فراموش شده برای مقابله با بدترین میکروبهای بیماریزا
یک آنتیبیوتیک که 40 سال پیش کشف شد و تا به امروز کنار گذاشته شده بود، میتواند به جریان داروسازی بازگشته و با بدترین میکروبهای بیماریزا مبارزه کند.
به گزارش رادیو نشاط ، همانطور که دانشمندان به دنبال راههای جدید برای مقابله با مشکل رو به رشد باکتریهای مقاوم در برابر دارو هستند؛ به یک استراتژی جدید دست یافتند تا با استفاده از تجزیه و تحلیل داروهای مدرن، آنتیبیوتیکهایی که در گذشته مورد استفاده قرار نداده بودند را مورد ارزیابی قرار دهند.
یکی از آنتی بیوتیکها، "اُکتاپپتین" (octapeptin)است که 40 سال پیش کشف شد، اما به دلیل در اولویت قرار گرفتن دیگر داروها این دارو توسط دانشمندان فراموش شد.
براساس یک مطالعه جدید بر روی این آنتیبیوتیک، یک تیم بینالمللی محققان بر این باورند که "اکتاپپتین" توانایی جایگزینی با "کولیستین"(colistin)، یکی از داروهایی که باکتریها قادر به پیشبینی آن شدهاند را دارد.
"مَت کوپر" (Matt Cooper)یکی از محققان دانشگاه کویینزلند استرالیا گفت: اکتاپپتینها در اواخر دهه 1970 کشف شدند، اما در آن زمان برای توسعه انتخاب نشدند.
دانشمندان براساس تجزیه و تحلیل جدید، بر این باورند که ساختار اکتاپپتین مشابه ساختار کولیستین است و طی درمان میتواند برای بدن کمتر سمی باشد.
و این به خصوص برای مقابله با نوعی از باکتری مقاوم به نام باکتریهای "گِرم منفی"(gram-negative) در شرایطی مانند ذات الریه، مننژیت، عفونتهای خونریزی و عفونتهای زخم یا جراحی قابل استفاده است.
کوپر افزود: اکتاپتین در آزمایش اولیه پیش از موعد اثرات ضد میکروبی قویتری را نسبت به کولیستین در برابر باکتریهای گرم منفی مقاوم نشان داد.
هنوز هم راهی طولانی برای توسعه و آزمایش این آنتیبیوتیک تازه کشف شده وجود دارد، اما محققان میگویند که این میتواند پایهای برای نسل جدید آنتیبیوتیکهایی که آماده مبارزه با عفونتهای تهدید کننده زندگی هستند، باشد.
کوپر گفت: در حالی که این تحقیق در مرحله اولیه است، کشف مجدد و بهینهسازی یک دارو فراموش شده راهی برای مبارزه با بدترین باکتریهای مقاوم به دارو است.
این تحقیق در مجله "زیستشناسی شیمیایی سلول"Cell Chemical Biology)) منتشر شده است.
https://www.sciencedaily.com/releases/2018/01/180125135556.htm